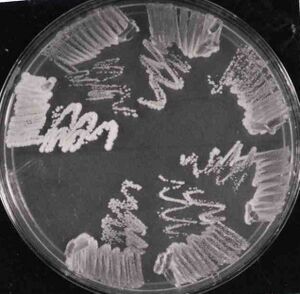
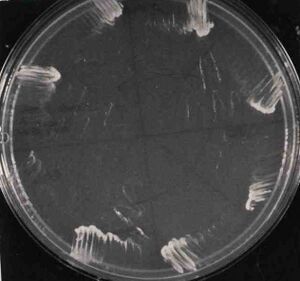
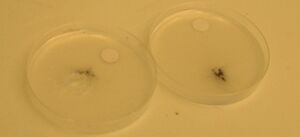
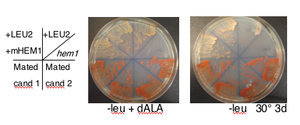
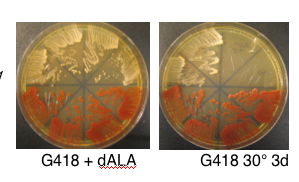
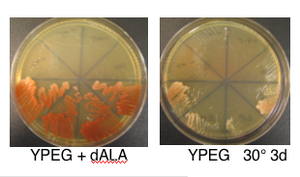

User talk:Nkuldell/mtDNA pt2
DNA Reagents
HEM1 reporter_Y00100 [1]
- HEM1 [2]
- 5-aminolevulinate synthase ("ALA synthase"), catalyzes the first step in the heme biosynthetic pathway [3]; an N-terminal signal sequence is required for localization to the mitochondrial matrix; expression is regulated by Hap2p-Hap3p
- nuclear gene is 1.647 kb [4], protein is 549 aa [5]
- SGD reports systematic deletion is inviable but also reports null is viable, heme and methionine auxotroph. Suggest we could select for mitochondrial expression of HEM1 in nuclear mutant by selection on -d-ALA, -heme or -met plates and measure expression levels with Western if antibody available (note: HEM1 antiserum described in very old paper [6], or epitope tagged.
- If fusion was directed to COX3 (instead of other regions of mito genome that will eventually want to clean up) then can select for integrants as respiration defective, as well as d-ALA independent growth. True respiration defect (e.g. cox mutn) will not grow on non-fermentable carbon source even with d-ala.
- heme req'd for...
- ergosterol biosynthesis pathway[7]
- fatty acid biosynthesis pathway [8]] , and
- methionine biosynthesis pathway [9]
though no step directly requiring heme seen from cursory look at biochemical pathways.
- Design of HEM1-HAm with DNA2.0
- ORF synthesis request File:Macintosh HD-Users-nkuldell-Desktop-HEM1-HAm synthreq1.rtf
- Sequence file sent from DNA 2.0 File:Macintosh HD-Users-nkuldell-Desktop-HEM1.txt
- ORF synthesis plus COX3 flanking sequence plus BB ends File:Macintosh HD-Users-nkuldell-Desktop-requestHEM1reporter-flank.rtf
- Sequence file sent from DNA 2.0 File:Macintosh HD-Users-nkuldell-Desktop-HEM1m withCOX3flanks.txt
- Quote:File:Macintosh HD-Users-nkuldell-Desktop-QuoteHEM1HAm COX3flank.txt
- Received DNA on 08.18.06 in strain "Stbl2" (invitrogen) stored as stock NB247
- If target to COX3 successful, can reuse this HEM1-HAm reporter from DNA2.0 by amplifying with long primers bearing different flanking sequence. Need about 19 bases as landing sequence and E. Sia paper [10] uses 48 bases of homology to see recombination (more precisely to see excision) at rate only 1/3 of rate with 100 bases homology. A few things to remember about using really long primers: IDT will synthesize them only at 250 uM scale, do not need HPLC purif but should include more (ask Brendan in Fred's lab how much more) in the PCR since the number of full lengths is not as great as with shorter oligos.
Strains
MH339
- Mark has nuclear HEM1 K/O with KanMX
- Mark has nuclear HEM1 K/O with KanMX
Genotype of yMH339: MATa ura3D0 his3D200 leu2D0 lys2-128d HAP1 hem1D::KanMX
Geneology note: yMH36 hem1D::KanMX #1 03/14/06
- nuclear K/O requires addition of 8,5-amino-levulinate to grow. Same compound is also called d-ALA and can be ordered from Sigma (A7793, 500 mg bottle to store dessicated at -20°). Stock is 20 mg/ml in dH20 and can store aliquots at -20° to freeze/thaw. Working concentration is 200 ug/ml to fully overcome HEM1 deletion by providing product of HEM1 catalyzed reaction. must spread 300 ul on plates of any kind for hem1 deletion strain to grow
- Mark believes there is a UV or spec method for measuring heme levels
from Tom Fox
strain request 07.14.06 File:Macintosh HD-Users-nkuldell-Desktop-StrainsReq'dTomFox.rtf
reply 07.17.06 File:Macintosh HD-Users-nkuldell-Desktop-StrainReq TFreply.rtf
strain request correspondence cont'd 07.17.06 File:Macintosh HD-Users-nkuldell-Desktop-SecondStrainRequestEmail.rtf
DFS160 (NY353)
MATalpha ura3-52 leu2D ade2-101 arg8D::URA3 kar1-1 rho0
- use for biolistic transformation
DFS168 (NY354)
MATa ura3D leu2-3,112 his4-519 arg8D::URA3 cox3D::ARG8m rho+
- ARG8 recoded for mitochondrial expression and complements nuclear deletion
CK520 (NY355)intronless mtDNA strain
MATa leu1 kar1-1 canR rho+mit+ no mitochondrial introns
- described in Seraphin PNAS 1987
- from Tom Fox's strain collection card

NY360
MATalpha ura3-52 leu2D ade2-101 arg8D::URA3 kar1-1 hem1::KanMX rho0
- candidate 3 from transformation of DFS160 (NY353) with product of PCR using primers FO2827 (aka MH107) and FO2828 (aka MH108) to replace ORF of HEM1 with KanMX (1.4 kb) from pRS400.
- other candidates from transformation are NY358, 359, and 361
- requires d-ALA for growth so don't forget to spread on plates and put in liq. media
- phenotypically G418R, Ura+ and Arg-
- use for biolistic transformation
- Phenotype

Biolistics 08.23.06
many thanks to Yasunori Hayashi and Ken Okamoto in his lab for hosting and teaching me today



Biolistics 09.05.06
with thanks to Stu Milstein in Marc Vidal's lab who kindly let me fire their gun at my yeast under vacuum

Media:Macintosh_HD-Users-nkuldell-Desktop-Biolistics_VidalLab.AVI

Biolistics 09.11.06
File:Macintosh HD-Users-nkuldell-Desktop-Biolistics NoScreen.AVI
File:Macintosh HD-Users-nkuldell-Desktop-Biolistics closeup.AVI


Primers
primers already made
- FO2827 (aka MH107) to replace ORF of HEM1 with pRS marker
5'-CCTCAATAATCATAACAGTACTTAGGTTTTTTTTTCAGTAGATTGTACTGAGAGTGCAC
- FO2828 (aka MH108) to replace ORF of HEM1 with pRS marker
5'-CTTGTACCTCTATCTCAGCCCATGCATATATTGGTTGTTCTGTGCGGTATTTCACACCG - FO2829 (aka MH109) to prime 170 bp upstm of HEM1 start codon
5'-TCTTCCTTTACACGCCTTCC - FO2830 (aka MH110) to prime 197 bp dwnstm from HEM1 stop codon
5'-CTACAGTTTAACCATTGCAG
- FO2828 (aka MH108) to replace ORF of HEM1 with pRS marker
project specific primers
- COX3_upstm_fwd (NO129) to check for insertion at COX3
5'-AATTTTATTATATAGTTTAAGGGATAATATTTTATTAAT-3'
This sequence was used in Y00100 to direct insertion of mtHEM1-HA to COX3
Primer maps to mt seq from 79113 to 79151, where COX3 is from 79213 to 80022
Primer is 39mer, Tm ~50
- COX3_dwstm_rev (N0130) to check for insertion at COX3
5'-TAAAATATATATATATAAATTATAATATATTAATTATTG-3'
This is reverse complement of sequence in Y00100 that was used to direct insertion of mtHEM1HA to COX3
Primer is 39mer, Tm~45
- COX3_upstm_59mer_fwd (NO131) to check for insertion at COX3
AAT TTT ATT ATA TAG TTT AAG GGA TAA TAT TTT ATT AAT ATT TTT TTT ATT TAT TTA TT
59mer, Tm~55
- COX3_dwstm_59mer_rev (NO132) to check for insertion at COX3
ATA TAT TAA TTA TTG TTA ATT ATT AAT AAT ATA TAT ATT AAT CAT TTA GAT ATA TAA TT
59 mer, Tm~54
- Y00100_ATG_rev (NO138)
GTG GAC ACA GCA GCA CTA CTG TTA CCA AAT CTG GCG AAT ATA GAA CGT TGC AT
Tm 68°
- COX2_74454toSTOP_fwd (NO139)
CAA TTA AGA TCG AAG CAG TAT CAT TAC CTA AAT TTT TGG AAT GAT TAA ATG AAC AAT AA
Tm 62°
Protein Tags
- Might want to epitope tag at C-terminus (N-terminus is used for mt import and probably shouldn't mess with this section for fusion). Possible tags are HA, c-myc or better still (if possible) might be alpha-complementing portion of b-gal. .
HA epitope tag
YPYDVPDYA (influenza hemagglutinin-HA-epitope)
Abcam antibody conjugated to HRP [11]
alpha-complementation
- Bacterial ref: Ullmann, Jacob, Monod (1967) JMB [12]
- Yeast ref: Abbas-Terki and Picard (1999) Eur J Biochem [13]
- Mammalian ref: Moosmann and Rusconi (1996) NAR [14]
and more recently changing affinity of alpha and omega fragments to look at protein translocation Wehrman, Casipit, Gewertz and Blau (2005) Nature Methods [15] - yeast alpha-frag defined as first 81 aa in [16].
Cutting Room Floor
BBa_Y00012
mitochondrial LYS12
- S. cerevisiae gene LYS12 [17] is required for the fourth step of lysine biosynthesis. It is normally encoded by the nuclear genome and the protein is imported to the mitochondria where it oxidatively decarboxylates homo-isocitrate to alpha-ketoadipate. Strains deleted for LYS12 are viable but show decreased growth in the absence of lysine. Part Y00012 is the S. cerevisiae LYS12 gene that has been recoded for expression in the mitochondria, which uses a different genetic code and separate transcription/translation machinery for expression mitochondrial genes. The part is start to stop flanked by biobrick ends so has no promoter for expression or sequences for recombination into the mitochondria.
Note 07.07.06 : lys12 from deletion set grows ~wt on SC-lys plates (unlike lys2 from deletion set). Check if the strain is correct by ordering primers outside of LYS12 (Winston has KanMX specific primers for inside = FO1310 (Tm 65) and FO1311 (Tm 57)) as well as LYS2 primer pair for positive control (also from Winston oligo ollection) LYS2up is -132 to -115 upstream of ATG +1, seq =5'-CGC-TGG-GAG-AAG-TTC-AAG-3' and LYS2down is 5'-GAA-GCT-GCC-ATT-AGC-AGAC-3'
Email'd info
1
From: "Barry Canton" Subject: Re: T7 RNAP in eukaryotes
Still here Natalie:) You can definitely get T7 transcription working in some eukaryotes, I'm not sure about yeast. I've included the two refs. I have below but there may be more. Also, thanks for the note about the clones, they will be very useful if the team decide to go that way. Barry
Abstract = {We have developed expression vectors that direct the synthesis of proteins from a common set of signals in both prokaryotic and eukaryotic cells. To allow transcription from a common promoter the vectors rely upon a phage RNA polymerase (RNAP). To direct initiation of translation to the same start codon the vectors utilize an internal ribosome entry site (IRES) from encephalomyocarditis virus (EMCV) that has been modified to include a prokaryotic ribosome-binding site (RBS) at an appropriate distance upstream from the desired start codon. These vectors provide levels of expression in eukaryotic cells that exceed those of a conventional RNAP-II-based system by 7-fold, and expression in bacterial cells at levels comparable to other phage RNAP-based systems. Inclusion of a lac repressor and a phage promoter/lac operator fusion element allows tight regulation. Cotransfection of eukaryotic cells with the expression vector and a vector that encodes the phage RNAP provides high-level transient expression without the need to construct specialized stable cell lines.
Author = {He, B and McAllister, W T and Durbin, R K}
Journal = {Gene}
Pages = {75-9}
Title = {Phage RNA polymerase vectors that allow efficient gene expression in both prokaryotic and eukaryotic cells.}
Volume = {164}
Year = {1995}
Abstract = {DNA coding for bacteriophage T7 RNA polymerase was ligated to a vaccinia virus transcriptional promoter and integrated within the vaccinia virus genome. The recombinant vaccinia virus retained infectivity and stably expressed T7 RNA polymerase in mammalian cells. Target genes were constructed by inserting DNA segments that code for beta-galactosidase or chloramphenicol acetyltransferase into a plasmid with bacteriophage T7 promoter and terminator regions. When cells were infected with the recombinant vaccinia virus and transfected with plasmids containing the target genes, the latter were expressed at high levels. Chloramphenicol acetyltransferase activity was 400-600 times greater than that observed with conventional mammalian transient-expression systems regulated either by the enhancer and promoter regions of the Rous sarcoma virus long terminal repeat or by the simian virus 40 early region. The vaccinia/T7 hybrid virus forms the basis of a simple, rapid, widely applicable, and efficient mammalian expression system.}
Author = {Fuerst, T R and Niles, E G and Studier, F W and Moss, B}
Journal = {Proc Natl Acad Sci U S A}
Title = {Eukaryotic transient-expression system based on recombinant vaccinia virus that synthesizes bacteriophage T7 RNA polymerase.}
Volume = {83}
Year = {1986}
-- Barry Canton Endy Lab Biological Engineering Division Massachusetts Institute of Technology
2
From Tom Fox at Cornell
Suject: mt T7 RNAP exp'n vectors/strains
Hi Natalie,
Aimee Dudley, whom I know from her days as a UMass undergrad, wrote me the day before yesterday for ..."a friend who's interested in using the our T7 system to do some mito. engineering." I guessed correctly that was you. I have two plasmids that may be of use to you from her work on this:
pT18, which expresses the T7 polymerase targeted to mitos from the ADC1 promoter.
pET3-COX2, which has the T7 promoter driving COX2 expression.
Unfortunately, I don't seem to have the yeast strain with the T7 promoter integrated into mtDNA upstream of COX2. Aimee is going to try to track that down in Amherst.
We'll send you those plasmids when we send you the strains you're going to ask for.
best wishes,
Tom
--
Thomas D. Fox
Professor
Department of Molecular Biology and Genetics
Biotechnology Building
Cornell University
Ithaca, NY 14853-2703
Phone 607-254-4835
FAX 607-255-6249
3
From Danielle Urban-Grimal in France
Re: HEM1 antiserum
Dear Dr Kuldell,
I'm just coming back from holidays and read your mail. Yes, an old story! However, you can still ask for the HEM1 antibody to Dr J-M CAMADRO. I know he has it. He will be back in his lab in around two weeks. His address is following.
Dr Jean-Michel Camadro
DR1 CNRS
Laboratoire d'Ingénierie des Protéines et Contrôle Métabolique
Dpt de Biologie des Génomes
INSTITUT JACQUES MONOD (UMR 7592 CNRS - Universités Paris 6 & 7)
Couloir 43-44
2 Place Jussieu, F-75251 Paris Cedex 05
Tel : 33 (0)1 44 27 81 70; Fax : 33 (0)1 44 27 57 16 >http://www.ijm.jussieu.fr/Ingenierie_proteines.php
Best Regards
Dr Urban-Grimal
Dr. Daniele Urban-Grimal Laboratoire Trafic Intracellulaire des Proteines chez la Levure Institut Jacques Monod -Tour 43 CNRS-Universites Paris 6 &7 2 place Jussieu F-75251 PARIS Cedex 05 France Tel: 33 1 44 27 99 92; Fax: 33 1 44 27 59 94 Email: grimalATijmDOTjussieuDOTfr [18]
Dear Dr. Urban-Grimal-
I am beginning a collaborative project at Harvard Medical School and MIT in which we would like to use HEM1 as a reporter in the S. cerevisiae mitochondria. A literature search revealed your very thorough description of the HEM1 gene in 1986 (Eur J Biochem 156:511), including a mention of an anti-ALA synthase antibody. I am writing with the hope that you could send an aliquot of that antiserum, although I realize that it is now 20 years old!
If the antiserum is unavailable but you are aware of another source, I would be grateful to know of it.
Thank you in advance for your help with these questions and requests,
Best wishes,
Natalie Kuldell